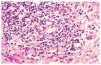
fig3

INTRODUCCION
Los pacientes con trastornos linfoproliferativos malignos, además de las complicaciones infecciosas, presentan con frecuencia manifestaciones cutáneas que se dividen en específicas, cuando la piel se haya infiltrada por estas mismas células malignas, e inespecíficas1 (tabla 1). En este último grupo se encuentran, entre otras, una erupción caracterizada por una eosinofilia tisular marcada, que en la clínica recuerda a las picaduras de insecto y que ha recibido diversas denominaciones2-12. Se ha observado este tipo de lesión no específica sobre todo en el contexto de la leucemia linfática crónica (LLC) de células B, que constituye la forma más frecuente de leucemia crónica en los países occidentales1. El porqué de esta asociación y su significado pronóstico son cuestiones aún en revisión. Presentamos nuestra experiencia con 5 casos que ilustran esta curiosa asociación.
PACIENTES Y MÉTODOS
Se incluyen 5 pacientes que desarrollaron en el contexto de una LLC una reacción similar a picadura de insecto. Se han recogido de forma retrospectiva, tras revisar nuestro archivo durante el período comprendido entre los años 1992 y 2002. Todos ellos tenían ya el diagnóstico de una LLC. El tiempo transcurrido desde el diagnóstico y la aparición de la dermatosis variaba entre 6 meses y 5 años. Los pacientes seguían controles en el servicio de hematología de nuestro hospital y todos ellos fueron visitados en el servicio de dermatología en el momento de presentar las lesiones cutáneas. En todos los casos se practicó una biopsia «en sacabocados».
Las biopsias se procesaron de forma convencional. Se fijaron en paraformaldehído tamponado al 10 % y se incluyeron en parafina. En todos los casos se realizaron tinciones con hematoxilina-eosina y un estudio inmunofenotípico completo empleando anticuerpos contra CD3 (Novocastra, Newcastle, Reino Unido), CD5 (Novocastra), CD20 (Dako, Dinamarca), CD79a (Dako) y CD23 (Novocastra). Las técnicas de inmunohistoquímica se procesaron de forma automatizada utilizando el dispositivo Autostainer (Dako). En todos los casos se realizó desenmascaramiento antigénico con autoclave y tampón citrato. Como sistema de detección se empleó EnVision+ (Dako). Los resultados se evaluaron de forma semicuantitativa; se establecieron cinco categorías en función de la cantidad de células que expresaba cada antígeno estudiado, definiendo la categoría + + + + cuando entre el 75 y el 100 % de las células del infiltrado eran inmunorreactivas; + + +, entre el 50 y el 75 %; + +, entre el 25 y el 50 %; +, entre el 0 y el 25 %, y , cuando ninguna célula se teñía con el anticuerpo empleado.
RESULTADOS
Las características clínicas de los casos recogidos se resumen en la tabla 2. Se trata de 3 mujeres y 2 varones, con edades comprendidas entre los 50 y los 85 años, todos ellos diagnosticados de LLC de células B. Tres pacientes se hallaban en un estadio precoz de la leucemia, por lo que no realizaban ningún tratamiento. Los otros dos recibían tratamiento con clorambucilo en el momento de presentar las lesiones cutáneas. El motivo de consulta fue, en todos ellos, la aparición brusca de una erupción pruriginosa de horas a pocos días de evolución. Sólo 2 pacientes (casos 1 y 4) referían a su vez febrícula vespertina y un síndrome gripal asociado a la erupción cutánea. Las lesiones elementales consistían en pápulas o placas eritematovioláceas, algunas con vesícula o costra central (fig. 1). El número de lesiones oscilaba entre uno y treinta. La distribución de la erupción también fue variable, siendo las extremidades la localización más frecuente. La época del año en que consultaron fue distinta para cada uno de ellos. Un paciente (caso 2) estaba ingresado en nuestro hospital en el momento del diagnóstico. Ninguno de los casos reconocía el antecedente de picadura de un insecto. El caso 1 refería durante los últimos 2 meses dos episodios similares con lesiones ampollosas en otras localizaciones, que curaron con la aplicación tópica de un antibiótico. En todos los casos figuraba el diagnóstico de picadura de insecto entre otras opciones de diagnóstico diferencial como toxicodermia, penfigoide ampolloso, celulitis, leucemia cutis o varicela. Uno de los pacientes (caso 5), presentaba además un dolor lancinante en la zona dorsolumbar izquierda, donde se apreciaron lesiones distintas en forma de vesículas con una base eritematosa, agrupadas, que seguían una distribución metamérica. En la citología de una de estas lesiones se observaron cambios citopáticos compatibles con una infección por virus herpes. Estas lesiones siguieron la evolución propia de un herpes zóster.
Fig. 1.--Lesiones ampollosas en el dorso de la extremidad superior.
En el estudio histológico de todas las biopsias se observó un infiltrado perivascular en la dermis superficial y profunda compuesto por linfocitos, polimorfonucleares y abundantes eosinófilos (figs. 2 y 3). La intensidad del infiltrado fue variable, siendo muy denso y con un gran número de eosinófilos en los casos 1 y 4, en los que además se observó un marcado edema en la dermis papilar con formación de una ampolla subepidérmica. El resultado del estudio inmunohistoquímico se resume en la tabla 3. En todos los casos existía un claro predominio de los linfocitos T (CD3, CD5) sobre los linfocitos B (CD20, CD79a) (fig. 4), excepto en el caso 1, donde el cociente T/B se igualó. En ninguna de las muestras se demostró positividad para CD23 en los infiltrados dérmicos, con la excepción de un único caso en el que las células CD23 positivas no coexpresaban marcadores B ni CD5.
Fig. 2.--Infiltrado inflamatorio que afecta a toda la dermis con distribución perivascular. (Hematoxilina-eosina, x10.)
Fig. 3.--Detalle del infiltrado linfohistiocitario rico en eosinófilos.
Fig. 4.--Inmunofenotipo del infiltrado linfoide que muestra predominio de CD3 (A), CD5 (B), sin expresión de CD79a (C) ni CD23 (D). (Inmunoperoxidasa, x100.)
En todos los casos las lesiones se resolvieron en un período corto de tiempo, entre 7 y 15 días, con o sin tratamiento. Sin embargo, al cabo de un mes, 3 pacientes (casos 1, 4 y 5) volvieron a presentar lesiones similares en otras localizaciones. Dos pacientes (casos 1 y 4) requirieron la administración de glucocorticoides por vía oral para la remisión del cuadro. Permanecieron sin lesiones durante el tratamiento, pero recidivaron de nuevo al finalizarlo. Respecto a la discrasia hematológica, 3 de los 5 pacientes (casos 1, 2 y 4) evolucionaron a un estadio más avanzado poco tiempo después del desarrollo de la dermatosis. Una de las pacientes (caso 1) falleció como consecuencia de la enfermedad hematológica al cabo de 8 meses.
DISCUSION
El primer autor en describir la asociación entre LLC y la reacción similar a picadura fue Weed3 en 1965 y desde entonces han aparecido otras publicaciones en la literatura médica4,5. En todas ellas se destaca que la LLC es la entidad en la que con mayor frecuencia se observa esta dermatosis, aunque también se ha descrito asociada a otros procesos como la inmunodeficiencia por el virus de la inmunodeficiencia humana (VIH-1)8, la agammaglobulinemia congénita7, la linfocitosis natural killer6,13 y otras neoplasias hematológicas9. Desde las primeras descripciones de la enfermedad3 llamó la atención la presencia constante de abundantes eosinófilos en el infiltrado. Por este motivo, el cuadro se relacionó con las picaduras de artrópodos, y se denominó a esta entidad reacción exagerada a picadura de insecto3-5, reacción similar a picadura10 o reacción tipo picadura en pacientes con trastornos hematológicos11. En la actualidad, todavía no se ha podido demostrar con certeza si la picadura del insecto es necesaria para desencadenar el proceso3,4,9, ya que la mayoría de los pacientes no recuerdan el antecedente de picadura ni existe un contexto epidemiológico favorable. Por otra parte, su carácter recidivante y su posible implicación pronóstica sugieren que, aunque la sintomatología sea similar a la de una picadura de insecto, su etiopatogenia es mucho más compleja10,12-14. Recientemente, el término «dermatosis eosinofílica de las enfermedades mieloproliferativas» ha sido propuesto por Byrd et al12 para referirse a aquellos pacientes con una discrasia hematológica que desarrollan una erupción cutánea papulosa o vesiculoampollosa, pruriginosa, resistente a los tratamientos habituales y con una marcada eosinofilia tisular, en los que se excluyen otras causas conocidas de la misma como enfermedades ampollosas, infecciones parasitarias, reacciones a fármacos o picaduras de insecto. Este término parece menos confuso, ya que no presupone la picadura de insecto como un desencadenante obligatorio en el desarrollo de la erupción, aunque queda por aclarar si se deben excluir aquellos pacientes en los que se recoge el antecedente claro de picadura12. De hecho, la inmunodeficiencia de estos pacientes combinada con algún estímulo inmunológico, como puede ser la picadura de un insecto, un fármaco o un virus, provocaría una anormal y exagerada capacidad reactiva de los eosinófilos para estimular la cascada de las citocinas5. Según esta hipótesis, es posible que en el caso 5, en el que la reactivación del virus de la varicela-zóster (herpes zóster) coincidió con la erupción tipo picadura de insecto, el virus actuase como estímulo inmunológico para desencadenar esta reacción. Para otros autores estaría motivada por un cierto grado de inmunodeficiencia de las células natural killer secundaria a la infección crónica por el virus de Epstein-Barr15, o de las células CD4 en el caso de los pacientes con infección por el VIH8. Otras hipótesis engloban a este tipo de reacción dentro de las variantes de penfigoide ampolloso9, a pesar de que la inmunofluorescencia directa siempre es negativa. Por el momento no se ha podido demostrar relación alguna entre el desarrollo de la erupción cutánea y el curso de la enfermedad, los parámetros de laboratorio o la quimioterapia recibida. Sin embargo, sí se ha observado que algunos enfermos con LLC, cuando presentan dicha reacción, siguen un curso rápidamente progresivo en lo que se refiere a la leucemia5,9,10. En nuestra experiencia, 3 de los 5 pacientes evolucionaron a un estadio más avanzado de su enfermedad hematológica e, incluso, uno de ellos falleció por este motivo a los pocos meses de iniciar el cuadro cutáneo. En la serie de Davis et al5 3 de los 8 pacientes descritos fallecieron al poco tiempo. Por otro lado, aunque la erupción suele aparecer al cabo de años del diagnóstico de la neoplasia, también se han descrito pacientes en los que la dermatosis precede al desarrollo de la LLC5,12. En nuestra serie, el diagnóstico de LLC siempre se estableció varios años antes de la manifestación cutánea. El carácter recidivante que con frecuencia se ha atribuido a este tipo de reacción no fue una constante en nuestra serie. Tres de los casos descritos recidivaron al poco tiempo y, de éstos, sólo uno lo hizo de forma reiterada. Esta paciente fue la que falleció poco tiempo después. El aspecto clínico de las lesiones ha sido en nuestra experiencia similar a lo descrito: pápulas y nódulos eritematosos, dolorosos y pruriginosos, de tamaño variable, localizados sobre todo en las áreas expuestas2,6, a veces con vesículas y ampollas purpúricas. También se ha descrito la asociación de las lesiones con febrícula y mal estado. Los hallazgos histopatológicos de este proceso consisten en un infiltrado linfohistiocitario con abundantes eosinófilos, que puede distribuirse tanto alrededor de los vasos como en el intersticio, puede afectar a la dermis superficial y/o profunda e, incluso, también al tejido celular subcutáneo2,9,13. En nuestros casos observamos también un infiltrado perivascular en la dermis, pero de intensidad y composición variable. El infiltrado estaba compuesto por linfocitos, neutrófilos, histiocitos y eosinófilos, siendo éstos especialmente numerosos en aquellos casos en los que la intensidad del infiltrado fue más importante. En el estudio inmunohistoquímico se demostró un claro predominio de los linfocitos T sobre los linfocitos B que, a su vez, eran negativos para los antígenos CD23 y CD5 (marcadores característicos de la LLC cuando se coexpresan en el linfocito B). Estos hallazgos, similares a los ya descritos por otros autores5,9,10,15, presuponen el carácter reactivo de esta entidad, ya que no se debe a la infiltración específica por las células neoplásicas, como pudo demostrarse en nuestros casos dada la negatividad para CD23 y CD5. Sin embargo, en una de las muestras, en la que el infiltrado fue muy abundante, el CD23 resultó positivo focalmente, aunque las células que expresaron este antígeno no eran linfocitos B (CD20 y CD79a negativos) ni coexpresaban CD5. En nuestra opinión, esas células CD23+ podrían corresponder a células de Langerhans y macrófagos activados, que también pueden expresar este antígeno. En aquellos casos en los que el infiltrado es muy intenso y puede plantearse el diagnóstico diferencial entre esta dermatosis reactiva y la infiltración de la dermis por las células neoplásicas, las tinciones con estos marcadores celulares pueden resultar de gran utilidad. Por lo que se refiere al tratamiento y dada la marcada tendencia a recidivar, a menudo es necesario administrar glucocorticoides por vía oral en dosis de 0,5-1 mg/kg/día2. La respuesta es espectacular pero, al disminuir la dosis, la recidiva es la regla. Otra buena opción de tratamiento, incluso para ahorrar corticoides, es la dapsona12. También se ha documentado una mejoría de las lesiones cutáneas al tratar de forma específica la LLC con quimioterapia5,12. Otros tratamientos ensayados son la inmunoglobulina intravenosa5,6 o la fototerapia (PUVA13 o UVB de banda estrecha12), más utilizada y con buenos resultados.